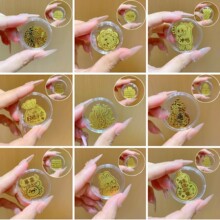
���999�֙C�Nˮؐͬ���2mg�S���N�Ą����������ƬС�YƷ���S

共 22725件
葫蘆貼
相關產品
所有類目
-
黑悟空國潮動漫手機貼 愛情財運雙主題手機裝飾貼 手機通用
-
手機貼足金999公主請發財黃金貼紙暴富金片財庫金卡冰箱貼手機
-
新款足金999草莓熊有錢花招財黃金擺件哆啦A夢蠟筆小新冰箱貼禮品
-
黃金手機貼足金2mg手機貼財庫起勢暴富順風順水深圳水貝同款禮品
-
新款足金999黃金手機貼公主請發財馬年暴富2mg帶背膠小禮品批發
-
新款足金999手機貼公主請發財含黃金2mg手機貼金片水貝同款批發
-
水貝同款足金999黃金手機貼貼公主請發財黃金貼片財庫金卡小禮品
-
新年金箔財庫金片個性賀歲卡片企業起勢卡牌伴手禮蛇年新款手機貼
-
水貝同款足金999鑽石公主請發財黃金手機貼引流可愛掛飾禮品批發
-
水貝黃金足金999手機金貼金片財暴富金箔片伴手禮公司紀念禮
-
999足金黃金手機貼公主請發財金片暴富冰箱貼紙財庫金卡禮品 批發
-
水貝黃金手機貼公主發財聚財庫好柿連連八方來財暴富禮物批發代發
-
黃金手機貼套裝足金999手機貼葫蘆招財進寶財庫帶背膠手機貼批發
-
黃金手機貼財庫起勢時來運轉暴富足金手機貼深圳水貝同款金貼禮物
-
足金999手機貼水貝同款暴富2mg黃金貼文創引流爆款金片小禮品工廠
-
黃金手機貼足金999暴富 公主請發財金片活動小禮品廠家批發
-
馬年足金999手機貼黃金手機貼公主請發財金片財庫金卡貼紙小禮品
-
爆款財庫卡手機貼金箔片開運金貼時來運轉八方來財起勢手機貼送禮
-
水貝黃金足金999手機金貼金片財暴富金箔片伴手禮公司紀念禮
-
手機貼財庫金卡時來運轉起勢百福小金卡禮品2026馬年順風順水七星
-
馬年黃金財神駕馬上到有錢鑰匙扣足金掛件廣告門店公關禮品批發
-
財庫手機貼足金999黃金公主請發財新年暴富貼紙財神手機貼紙禮品
-
公主請發財暴富財神爺招財貓足金999手機貼紙后背貼符批發可定制
-
黃金手機貼足金999公主請發財平安喜樂起勢財庫手機背膠金貼禮品
-
抖音爆款手機貼招財貓平安喜樂招財貓財批發 顏色 葫蘆貼、招財貓、元寶、招財L、爆單貼、平安喜樂、招財納福、平安貼、暴美F、暴富貼、招財進寶
-
馬年黃金手機貼暴富紅盒子財庫有錢花禮盒公主請發財金榜題名禮品
-
手機貼禮盒裝財庫葫蘆足金999手機貼紙禮品引流廠家批發暴富財庫
-
黃金手機貼足金999公主請發財金片手機后背貼金店引流實用小禮品
-
水貝足金999手機貼公主請發財黃金貼紙2mg一夜暴富金片金卡冰箱貼
-
足金黃金手機貼喜氣洋洋有求幣應中國心金箔招財貓暴富金卡金片貼
-
黃金手機貼2mg足金999手機貼紙創意卡通中國心唯有你文創禮品批發
-
馬年新款黃金手機貼公主請發財暴富大吉大利背膠廠家小禮品批發
-
足金999公主請發財暴富黃金手機貼財庫招財貓直播創意引流送人禮
-
黃金公主請發財千萬兩招財貓貼紙暴富金片財庫金卡手機貼
-
爆款財庫卡手機貼金箔片開運金貼時來運轉八方來財起勢手機貼送禮 顏色 財庫單帖(約5*6.3cm)、順字單貼(約5*6.3cm)、起勢單帖(約5*6.3cm)、時來運轉單貼(約5*6.3cm)、五路財神單帖(約4*7cm)、招財令單帖(約2*4.5cm)、超大葫蘆單貼、日進斗金單卡(不帶背膠,約6.6*4.3cm)、財庫在此+懸浮盒+隨機字條、吉福大順+懸浮盒+隨機字條、時來運轉+懸浮盒+隨機字條、起勢+懸浮盒+隨機字條、五路財神+懸浮盒+隨機字條、超大葫蘆貼++懸浮盒+隨機字條、日進斗金+懸浮盒+隨機字條、懸浮盒一個
-
樹脂冰箱貼 中國風冰箱磁力 金元寶 金花生配件立體家居裝飾貼
-
黃金手機貼來圖定制足金999暴富冰箱貼加LOGO包裝活動小禮品定制
-
馬年聚寶盆大葫蘆手機貼日進斗金貼紙裝飾冰箱殼仿金箔片紅色盒
-
抖音直播同款金箔招財令手機貼黃金色貼紙正財神趙公明活動小禮品
-
深圳水貝同款足金999暴富財庫招財貓手機貼背膠金貼引流金店禮品